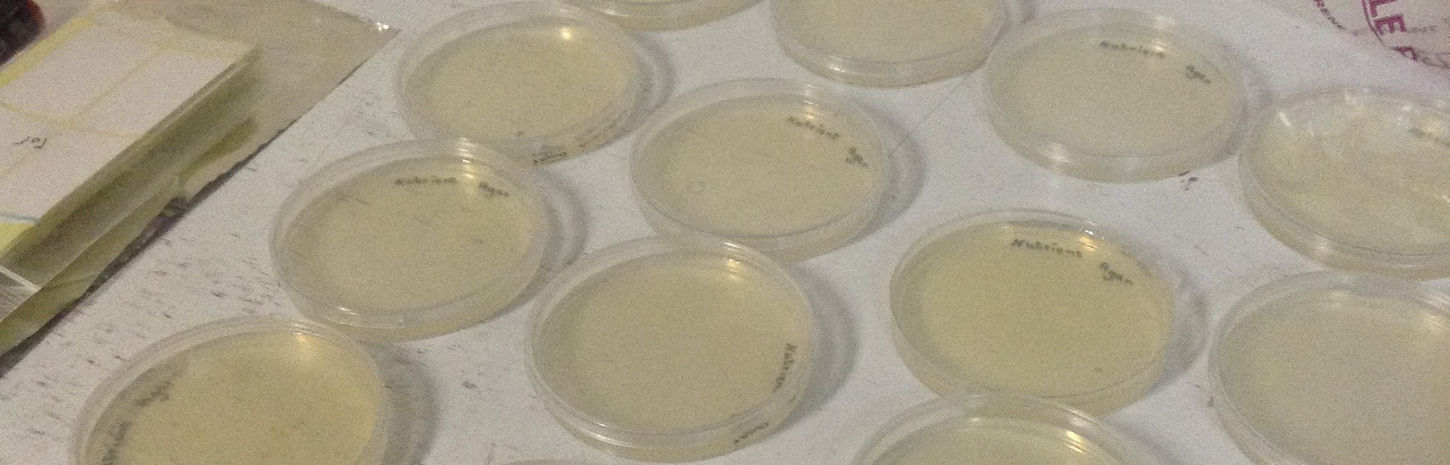

top of page
CULTIVATION, ISOLATION AND MICROSCOPY (2015)
A Real Success
In our Biolab we have made range of observations, one of them was Microscopy, We had made Nutrient Agar with the usage of our own magnetic Stirrer we had made in the lab and, cultivate, grow, isolate and bacteria, then add methylene blue and observe the result and microscope it, you may see the result in pictures, the bacteria like MG, leaf and etc., has been taken into this process. This Research has been done during BioHack Academy Physically in University of Tehran from Waag Society (in distance) joint with Tehran's Fablab (Carbon Idea)

CULTIVATION, ISOLATION AND MICROSCOPY (2015): Project
CULTIVATION, ISOLATION AND MICROSCOPY (2015): ProGallery_Widget
bottom of page